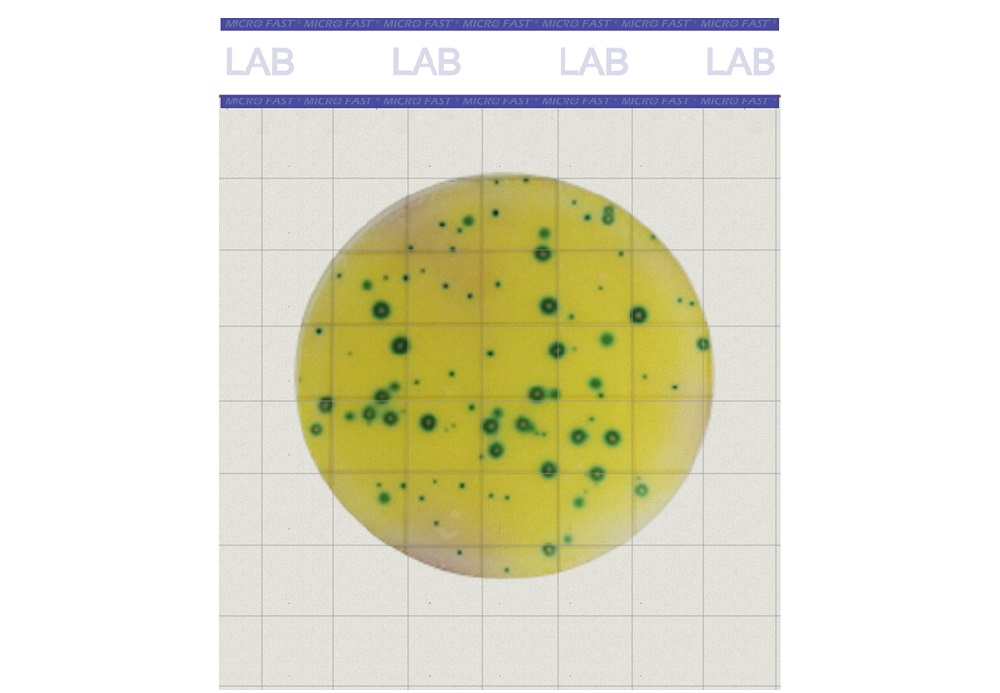

Count plate
測試片/培養基
咨詢服務
4000-222-191
Service Network
服務網絡


測試片/培養基
Count plate

魯公網安備37110202000421號
魯公網安備37110202000421號